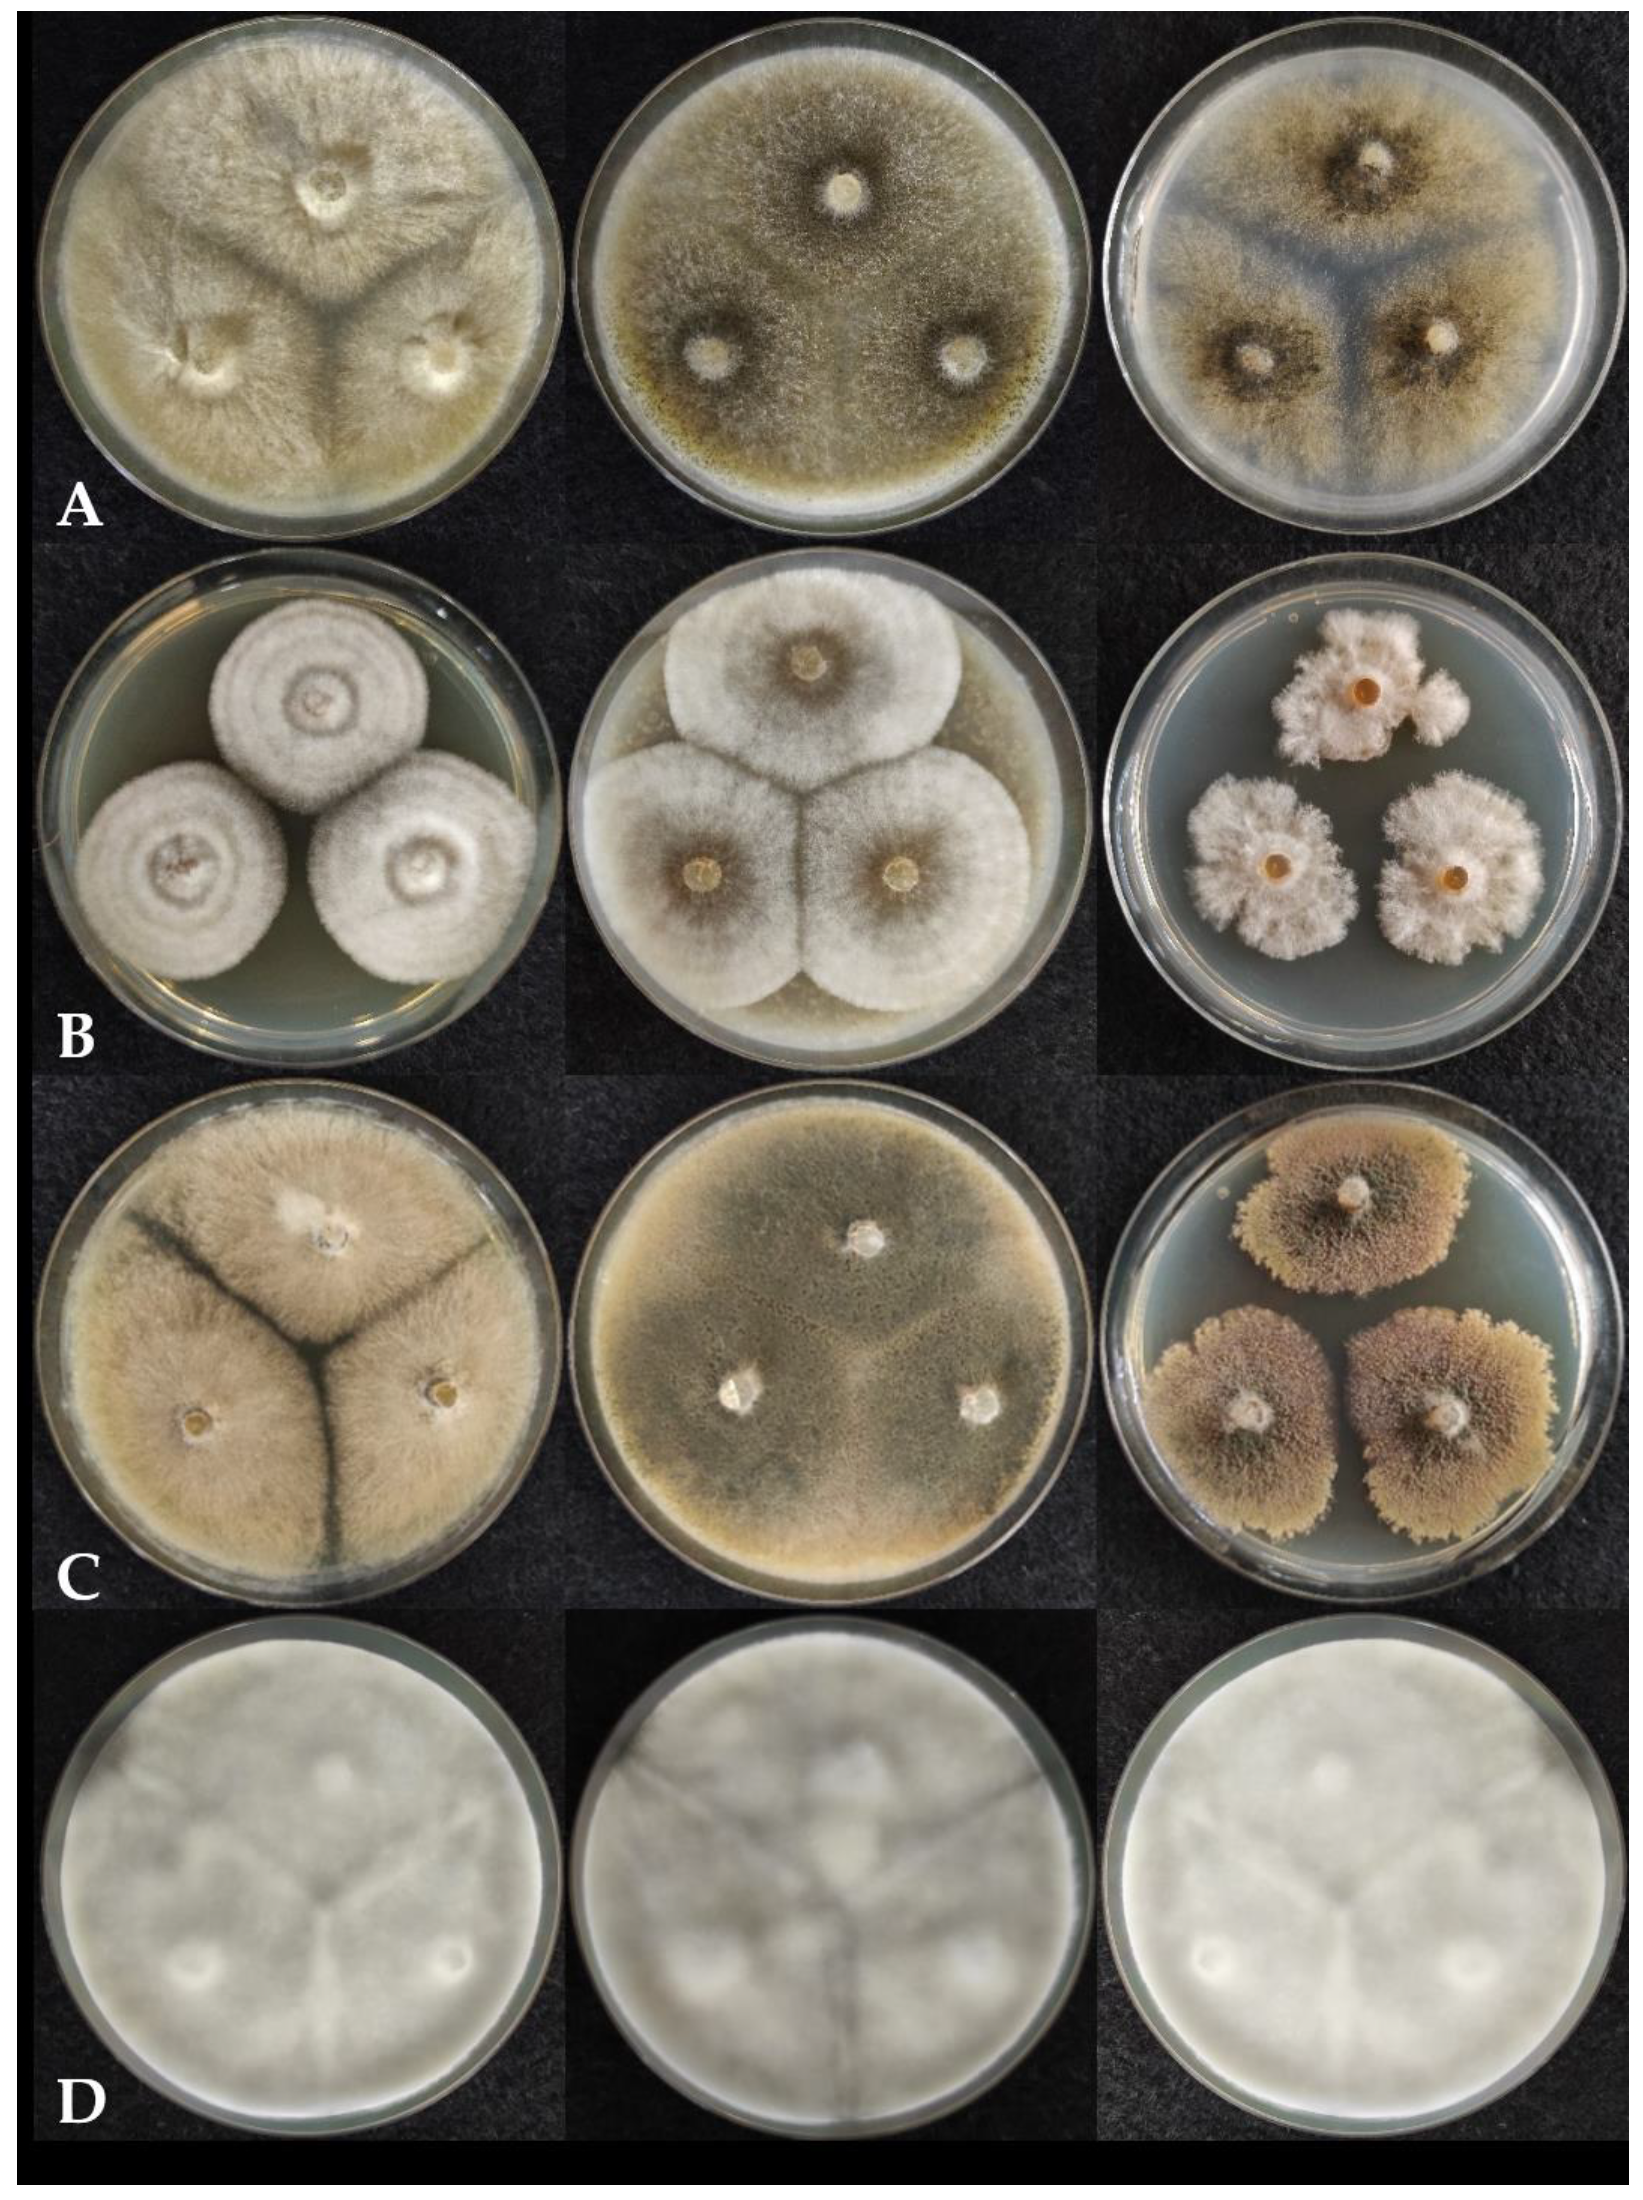
Pathogens 10 01133 g002

Chaetomium and Chaetomium-like Species from European Indoor Environments Include Dichotomopilus finlandicus sp. nov.
Abstract
1. Introduction
2. Results
2.1. Morphological Features of the Isolated Chaetomium Strains
2.2. Phylogeny and Taxonomy
2.3. Physiological Characterization of the Isolated Chaetomium and Chaetomium-like Strains
3. Discussion
4. Materials and Methods
4.1. Sample Collection and Isolation
4.2. Morphological Characterization
4.3. DNA Extraction, Identification, and Phylogenetic Analysis
4.4. Enzyme Production
4.5. Temperature Profiling
Author Contributions
Funding
Institutional Review Board Statement
Informed Consent Statement
Data Availability Statement
Conflicts of Interest
References
- Rodríguez, K.; Stchigel, A.; Guarro, J. Three new species of Chaetomium from soil. Mycologia 2002, 94, 116–126. [Google Scholar] [CrossRef] [PubMed]
 - Wang, X.W.; Wang, X.L.; Liu, F.J.; Zhao, X.M.; Li, J.; Cai, L. Phylogenetic assessment of Chaetomium indicum and allied species, with the introduction of three new species and epitypification of C. funicola and C. indicum. Mycol. Prog. 2014, 13, 719–732. [Google Scholar] [CrossRef]
 - Došen, I.; Nielsen, K.F.; Clausen, G.; Andersen, B. Potentially harmful secondary metabolites produced by indoor Chaetomium species on artificially and naturally contaminated building materials. Indoor Air 2017, 27, 34–46. [Google Scholar] [CrossRef] [PubMed]
 - Andersen, B.; Frisvad, J.C.; Søndergaard, I.; Rasmussen, I.S.; Larsen, L.S. Associations between fungal species and water-damaged building materials. Appl. Environ. Microbiol. 2011, 77, 4180–4188. [Google Scholar] [CrossRef]
 - Salo, J.M.; Kedves, O.; Mikkola, R.; Kredics, L.; Andersson, M.A.; Kurnitski, J.; Salonen, H. Detection of Chaetomium globosum, Ch. cochliodes and Ch. rectangulare during the diversity tracking of mycotoxin-producing Chaetomium-like isolates obtained in buildings in Finland. Toxins 2020, 12, 443. [Google Scholar] [CrossRef]
 - Castagnoli, E.; Mikkola, R.; Vornanen-Winquist, C.; Andersson, M.; Kredics, L.; Marik, T.; Kurnitski, J.; Salonen, H. Indoor Chaetomium-like isolates; resistance to chemicals, fluorescence and mycotoxin production. Sisäilmastoseminaari 2017, 35, 227–232. [Google Scholar]
 - Wang, X.W.; Houbraken, J.; Groenewald, J.Z.; Meijer, M.; Andersen, B.; Nielsen, K.F.; Crous, P.W.; Samson, R.A. Diversity and taxonomy of Chaetomium and Chaetomium-like fungi from indoor environments. Stud. Mycol. 2016, 84, 145–224. [Google Scholar] [CrossRef]
 - Stiller, M.J.; Rosenthal, S.; Summerbell, R.C.; Pollack, J.; Chan, A. Onychomycosis of the toenails caused by Chaetomium globosum. J. Am. Acad. Dermatol. 1992, 26, 775–776. [Google Scholar] [CrossRef]
 - Aspiroz, C.; Gené, J.; Rezusta, A.; Charlez, L.; Summerbell, R.C. First Spanish case of onychomycosis caused by Chaetomium globosum. Med. Mycol. 2007, 45, 279–282. [Google Scholar] [CrossRef] [PubMed]
 - Hwang, S.M.; Suh, M.K.; Ha, G.Y. Onychomycosis due to nondermatophytic molds. Ann. Dermatol. 2012, 24, 175–180. [Google Scholar] [CrossRef] [PubMed]
 - Kim, D.M.; Lee, M.H.; Suh, M.K.; Ha, G.Y.; Kim, H.; Choi, J.S. Onychomycosis caused by Chaetomium globosum. Ann. Dermatol. 2013, 25, 232–236. [Google Scholar] [CrossRef]
 - Shi, D.; Lu, G.; Mei, H.; de Hoog, G.S.; Zheng, H.; Liang, G.; Shen, Y.; Li, T.; Liu, W. Onychomycosis due to Chaetomium globosum with yellowish black discoloration and periungual inflammation. Med. Mycol. Case Rep. 2016, 13, 12–16. [Google Scholar] [CrossRef] [PubMed]
 - Hubka, V.; Mencl, K.; Skorepova, M.; Lyskova, P.; Zalabska, E. Phaeohyphomycosis and onychomycosis due to Chaetomium spp., including the first report of Chaetomium brasiliense infection. Med. Mycol. 2011, 49, 724–733. [Google Scholar] [CrossRef] [PubMed][Green Version]
 - Abbott, S.P.; Sigler, L.; McAleer, R.; McGough, D.A.; Rinaldi, M.G.; Mizell, G. Fatal cerebral mycoses caused by the ascomycete Chaetomium strumarium. J. Clin. Microbiol. 1995, 33, 2692–2698. [Google Scholar] [CrossRef] [PubMed]
 - Thomas, C.; Mileusnic, D.; Carey, R.B.; Kampert, M.; Anderson, D. Fatal Chaetomium cerebritis in a bone marrow transplant patient. Hum. Pathol. 1999, 874–879. [Google Scholar] [CrossRef]
 - Barron, M.A.; Sutton, D.A.; Veve, R.; Guarro, J.; Rinaldi, M.; Thompson, E.; Cagnoni, P.J.; Moultney, K.; Madinger, N.E. Invasive mycotic infections caused by Chaetomium perlucidum, a new agent of cerebral phaeohyphomycosis. J. Clin. Microbiol. 2003, 41, 5302–5307. [Google Scholar] [CrossRef][Green Version]
 - Gao, K.; Liu, X.; Kang, Z.; Mendgen, K. Mycoparasitism of Rhizoctonia solani by endophytic Chaetomium spirale ND35: Ultrastructure and cytochemistry of the interaction. J. Phytopathol. 2005, 153, 280–290. [Google Scholar] [CrossRef]
 - Ding, G.; Song, Y.C.; Chen, J.R.; Xu, C.; Ge, H.M.; Wang, X.T.; Tan, R.X. Chaetoglobosin U, a cytochalasan alkaloid from endophytic Chaetomium globosum IFB-E019. J. Nat. Prod. 2006, 69, 302–304. [Google Scholar] [CrossRef] [PubMed]
 - Sharma, R.; Kulkarni, G.; Sonawane, M.S.; Shouche, Y.S. A new endophytic species of Chaetomium from Jatropha podagrica. Mycotaxon 2013, 124, 117–126. [Google Scholar] [CrossRef]
 - Kamat, S.; Kumari, M.; Sajna, K.V.; Jayabaskaran, C. Endophytic fungus, Chaetomium globosum, associated with marine green alga, a new source of Chrysin. Sci. Rep. 2020, 10, 18726. [Google Scholar] [CrossRef]
 - Lakshmikant; Kamal; Mathur, S.N. Cellulolytic activities of Chaetomium globosum on different cellulosic substrates. World J. Microbiol. Biotechnol. 1990, 6, 23–26. [Google Scholar] [CrossRef]
 - Abdel-Azeem, A.M.; Gherbawy, Y.A.; Sabry, A.M. Enzyme profiles and genotyping of Chaetomium globosum isolates from various substrates. Plant Biosyst. 2016, 150, 420–428. [Google Scholar] [CrossRef]
 - Wanmolee, W.; Sornlake, W.; Rattanaphan, N.; Suwannarangsee, S.; Laosiripojana, N.; Champreda, V. Biochemical characterization and synergism of cellulolytic enzyme system from Chaetomium globosum on rice straw saccharification. BMC Biotechnol. 2016, 16, 82. [Google Scholar] [CrossRef]
 - Zhou, Q.; Jia, J.; Ji, P.; Han, C. A novel application potential of GH6 cellobiohydrolase ctcel6 from thermophilic Chaetomium thermophilum for gene cloning, heterologous expression and biological characterization. Int. J. Agric. Biol. 2017, 19, 355–362. [Google Scholar] [CrossRef]
 - Li, H.; Liao, Z.B.; Tang, D.; Han, W.B.; Zhang, Q.; Gao, J.M. Polyketides from two Chaetomium species and their biological functions. J. Antibiot. 2018, 71, 677–681. [Google Scholar] [CrossRef]
 - Wang, Z.; Jia, S.; Cui, J.; Qu, J.; Yue, Y.; Sun, Q.; Zhang, H. Antioxidant activity of a polysaccharide produced by Chaetomium globosum CGMCC 6882. Int. J. Biol. Macromol. 2019, 141, 955–960. [Google Scholar] [CrossRef]
 - Serena, C.; Ortoneda, M.; Capilla, J.; Pastor, F.J.; Sutton, D.A.; Rinaldi, M.G.; Guarro, J. In vitro activities of new antifungal agents against Chaetomium spp. and inoculum standardization. Antimicrob. Agents Chemother. 2003, 47, 3161–3164. [Google Scholar] [CrossRef] [PubMed]
 - Jiao, W.; Feng, Y.; Blunt, J.W.; Cole, A.L.J.; Munro, M.H.G. Chaetoglobosins Q, R, and T, three further new metabolites from Chaetomium globosum. J. Nat. Prod. 2004, 67, 1722–1725. [Google Scholar] [CrossRef]
 - Park, J.H.; Gyung, J.C.; Kyoung, S.J.; He, K.L.; Heung, T.K.; Kwang, Y.C.; Kim, J.C. Antifungal activity against plant pathogenic fungi of chaetoviridins isolated from Chaetomium globosum. FEMS Microbiol. Lett. 2005, 252, 309–313. [Google Scholar] [CrossRef]
 - Huang, S.; Chen, H.; Li, W.; Zhu, X.; Ding, W.; Li, C. Bioactive chaetoglobosins from the mangrove endophytic fungus Penicillium chrysogenum. Mar. Drugs 2016, 14, 172. [Google Scholar] [CrossRef]
 - Yan, W.; Cao, L.L.; Zhang, Y.Y.; Zhao, R.; Zhao, S.S.; Khan, B.; Ye, Y.H. New metabolites from endophytic fungus Chaetomium globosum CDW7. Molecules 2018, 23, 2873. [Google Scholar] [CrossRef]
 - Chovanová, K.; Zámocký, M. Detection of the antibacterial effect of Chaetomium cochliodes Palliser CCM F-232 based on agar plugs and unprocessed fungal substances from cultivation media. Biologia 2016, 71, 1204–1211. [Google Scholar] [CrossRef]
 - Dissanayake, R.K.; Ratnaweera, P.B.; Williams, D.E.; Wijayarathne, C.D.; Wijesundera, R.L.C.; Andersen, R.J.; de Silva, E.D. Antimicrobial activities of endophytic fungi of the Sri Lankan aquatic plant Nymphaea nouchali and chaetoglobosin A and C, produced by the endophytic fungus Chaetomium globosum. Mycology 2016, 7, 1–8. [Google Scholar] [CrossRef]
 - Gao, W.; He, Y.; Li, F.; Chai, C.; Zhang, J.; Guo, J.; Chen, C.; Wang, J.; Zhu, H.; Hu, Z.; et al. Antibacterial activity against drug-resistant microbial pathogens of cytochalasan alkaloids from the arthropod-associated fungus Chaetomium globosum TW1-1. Bioorg. Chem. 2019, 83, 98–104. [Google Scholar] [CrossRef]
 - Wang, Z.; Xue, R.; Cui, J.; Wang, J.; Fan, W.; Zhang, H.; Zhan, X. Antibacterial activity of a polysaccharide produced from Chaetomium globosum CGMCC 6882. Int. J. Biol. Macromol. 2019, 125, 376–382. [Google Scholar] [CrossRef] [PubMed]
 - Wani, N.; Khanday, W.; Tirumale, S. Evaluation of In vitro antioxidant potential of active metabolite constituents of different extracts of Chaetomium cupreum-SS02 by spectrophotometric method. Matrix Sci. Pharma 2020, 4, 50. [Google Scholar] [CrossRef]
 - Attia, E.; Dashora, K.; Abdel-azeem, A. A potential antimicrobial, extracellular enzymes, and antioxidants resource: Endophytic fungi associated with medicinal plants. Int. J. Biosci. 2020, 17, 119–132. [Google Scholar] [CrossRef]
 - Khan, B.; Yan, W.; Wei, S.; Wang, Z.; Zhao, S.; Cao, L.; Rajput, N.A.; Ye, Y. Nematicidal metabolites from endophytic fungus Chaetomium globosum YSC5. FEMS Microbiol. Lett. 2019, 366, fnz169. [Google Scholar] [CrossRef]
 - Hu, Y.; Zhang, W.; Zhang, P.; Ruan, W.; Zhu, X. Nematicidal activity of chaetoglobosin A poduced by Chaetomium globosum NK102 against Meloidogyne incognita. J. Agric. Food Chem. 2013, 61, 41–46. [Google Scholar] [CrossRef]
 - Chen, C.; Tong, Q.; Zhu, H.; Tan, D.; Zhang, J.; Xue, Y.; Yao, G.; Luo, Z.; Wang, J.; Wang, Y.; et al. Nine new cytochalasan alkaloids from Chaetomium globosum TW1-1 (Ascomycota, Sordariales). Sci. Rep. 2016, 6, 18711. [Google Scholar] [CrossRef]
 - Ruan, B.H.; Yu, Z.F.; Yang, X.Q.; Yang, Y.B.; Hu, M.; Zhang, Z.X.; Zhou, Q.Y.; Zhou, H.; Ding, Z.T. New bioactive compounds from aquatic endophyte Chaetomium globosum. Nat. Prod. Res. 2018, 32, 1050–1055. [Google Scholar] [CrossRef]
 - Wang, Z.; Chen, P.; Tao, N.; Zhang, H.; Li, R.; Zhan, X.; Wang, F.; Shen, Y. Anticancer activity of polysaccharides produced from glycerol and crude glycerol by an endophytic fungus Chaetomium globosum CGMCC 6882 on human lung cancer A549 cells. Biomolecules 2018, 8, 171. [Google Scholar] [CrossRef] [PubMed]
 - Senthil Kumar, V.; Kumaresan, S.; Tamizh, M.M.; Hairul Islam, M.I.; Thirugnanasambantham, K. Anticancer potential of NF-κB targeting apoptotic molecule “flavipin” isolated from endophytic Chaetomium globosum. Phytomedicine 2019, 61, 152830. [Google Scholar] [CrossRef]
 - Wani, N.; Khanday, W.; Tirumale, S. Biosynthesis of iron oxide nanoparticles using ethyl acetate extract of Chaetomium cupreum and their anticancer activity. Matrix Sci. Pharma 2020, 4, 23. [Google Scholar] [CrossRef]
 - Wijeratne, E.M.K.; Turbyville, T.J.; Fritz, A.; Whitesell, L.; Gunatilaka, A.A.L. A new dihydroxanthenone from a plant-associated strain of the fungus Chaetomium globosum demonstrates anticancer activity. Bioorg. Med. Chem. 2006, 14, 7917–7923. [Google Scholar] [CrossRef]
 - Ming Ge, H.; Yun Zhang, W.; Ding, G.; Saparpakorn, P.; Chun Song, Y.; Hannongbua, S.; Xiang Tan, R. Chaetoglobins A and B, two unusual alkaloids from endophytic Chaetomium globosum culture. Chem. Commun. 2008, 45, 5978–5980. [Google Scholar] [CrossRef] [PubMed]
 - Thohinung, S.; Kanokmedhakul, S.; Kanokmedhakul, K.; Kukongviriyapan, V.; Tusskorn, O.; Soytong, K. Cytotoxic 10-(indol-3-yl)-[13]cytochalasans from the fungus Chaetomium elatum ChE01. Arch. Pharm. Res. 2010, 33, 1135–1141. [Google Scholar] [CrossRef]
 - Li, H.; Xiao, J.; Gao, Y.Q.; Tang, J.J.; Zhang, A.L.; Gao, J.M. Chaetoglobosins from Chaetomium globosum, an endophytic fungus in ginkgo biloba, and their phytotoxic and cytotoxic activities. J. Agric. Food Chem. 2014, 62, 3734–3741. [Google Scholar] [CrossRef]
 - Zheng, Q.C.; Kong, M.Z.; Zhao, Q.; Chen, G.D.; Tian, H.Y.; Li, X.X.; Guo, L.D.; Li, J.; Zheng, Y.Z.; Gao, H. Chaetoglobosin Y, a new cytochalasan from Chaetomium globosum. Fitoterapia 2014, 93, 126–131. [Google Scholar] [CrossRef]
 - Hamed Eman, M.H. Anticancer compounds from Chaetomium globosum. Biochem. Anal. Biochem. 2015, 4, 174. [Google Scholar] [CrossRef]
 - Chen, C.; Shao, Y.; Tao, Y.; Wen, H. Optimization of dynamic microwave-assisted extraction of Armillaria polysaccharides using RSM, and their biological activity. LWT-Food Sci. Technol. 2015, 64, 1263–1269. [Google Scholar] [CrossRef]
 - Wang, Z.; Liu, X.; Bao, Y.; Wang, X.; Zhai, J.; Zhan, X.; Zhang, H. Characterization and anti-inflammation of a polysaccharide produced by Chaetomium globosum CGMCC 6882 on LPS-induced RAW 264.7 cells. Carbohydr. Polym. 2021, 251, 117129. [Google Scholar] [CrossRef] [PubMed]
 - Madbouly, A.K.; Abdel-Aziz, M.S.; Abdel-Wahhab, M.A. Biosynthesis of nanosilver using Chaetomium globosum and its application to control Fusarium wilt of tomato in the greenhouse. IET Nanobiotechnol. 2017, 11, 702–708. [Google Scholar] [CrossRef]
 - El-Mohamedy, R.S.R.; El-Gamal, N.G.; El-Shamy, A.R.; Atalla, S.M.M. Biosynthesis of zinc nanoparticles and its effect on enzymes production by Bacillus subtilis and Pseudomonas fluorescens using different agricultural wastes. Int. J. Agric. Technol. 2018, 14, 833–844. [Google Scholar]
 - Wang, X.W.; Zheng, R.Y. Chaetomium acropullum sp. nov. (Chaetomiaceae, Ascomycota), a new psychrotolerant mesophilic species from China. Nova Hedwigia 2005, 80, 413–417. [Google Scholar] [CrossRef]
 - Abdel-Azeem, A.M.; Abu-Elsaoud, A.M.; Abo Nahas, H.H.; Abdel-Azeem, M.A.; Balbool, B.A.; Mousa, M.K.; Ali, N.H.; Darwish, A.M.G. Biodiversity and industrial applications of genus Chaetomium. In Industrially Important Fungi for Sustainable Development; Abdel-Azeem, A.M., Yadav, A.N., Yadav, N., Usmani, Z., Eds.; Springer: Cham, Switzerland, 2021; Volume 1, pp. 147–206. [Google Scholar]
 - Gatumbi, R.W.; Kung’u, J.N. Notes on species of the genus Chaetomium from Kenya. East. Afr. Agric. For. J. 1994, 60, 79–89. [Google Scholar] [CrossRef]
 - Udagawa, S.I. A new species of Chaetomium from house dust. Mycoscience 1997, 38, 399–402. [Google Scholar] [CrossRef]
 - Andersen, B.; Nissen, A.T. Evaluation of media for detection of Stachybotrys and Chaetomium species associated with water-damaged buildings. Int. Biodeterior. Biodegrad. 2000, 46, 111–116. [Google Scholar] [CrossRef]
 - Piecková, E. In vitro toxicity of indoor Chaetomium kunze ex fr. Ann. Agric. Environ. Med. 2003, 10, 9–14. [Google Scholar]
 - Vornanen-Winqvist, C.; Järvi, K.; Andersson, M.A.; Duchaine, C.; Létourneau, V.; Kedves, O.; Kredics, L.; Mikkola, R.; Kurnitski, J.; Salonen, H. Exposure to indoor air contaminants in school buildings with and without reported indoor air quality problems. Environ. Int. 2020, 141, 105781. [Google Scholar] [CrossRef] [PubMed]
 - McMullin, D.R.; Sumarah, M.W.; Miller, J.D. Chaetoglobosins and azaphilones produced by Canadian strains of Chaetomium globosum isolated from the indoor environment. Mycotoxin Res. 2013, 29, 47–54. [Google Scholar] [CrossRef] [PubMed]
 - Fogle, M.R.; Douglas, D.R.; Jumper, C.A.; Straus, D.C. Growth and mycotoxin production by Chaetomium globosum. Mycopathologia 2007, 164, 49–56. [Google Scholar] [CrossRef]
 - Andersen, B.; Dosen, I.; Lewinska, A.M.; Nielsen, K.F. Pre-contamination of new gypsum wallboard with potentially harmful fungal species. Indoor Air 2017, 27, 6–12. [Google Scholar] [CrossRef]
 - Vornanen-Winqvist, C.; Järvi, K.; Toomla, S.; Ahmed, K.; Andersson, M.A.; Mikkola, R.; Marik, T.; Kredics, L.; Salonen, H.; Kurnitski, J. Ventilation positive pressure intervention effect on indoor air quality in a school building with moisture problems. Int. J. Environ. Res. Public Health 2018, 15, 230. [Google Scholar] [CrossRef]
 - Castagnoli, E.; Salo, J.; Toivonen, M.S.; Marik, T.; Mikkola, R.; Kredics, L.; Vicente-Carrillo, A.; Nagy, S.; Andersson, M.T.; Andersson, M.A.; et al. An evaluation of boar spermatozoa as a biosensor for the detection of sublethal and lethal toxicity. Toxins 2018, 10, 463. [Google Scholar] [CrossRef]
 - Andersen, A.A. New sampler for the collection, sizing, and enumeration of viable airborne particles. J. Bacteriol. 1958, 76, 471–484. [Google Scholar] [CrossRef]
 - Kedves, A.; Rónavári, A.; Kónya, Z. Long-term effect of graphene oxide on the aerobic granular sludge wastewater treatment process. J. Environ. Chem. Eng. 2021, 9, 104853. [Google Scholar] [CrossRef]
 - Löytynoja, A. Phylogeny-aware alignment with PRANK. Meth. Mol. Biol. 2014, 1079, 155–170. [Google Scholar] [CrossRef]
 - Salinas, N.R.; Little, D.P. 2matrix: A utility for indel coding and phylogenetic matrix concatenation. Appl. Plant Sci. 2014, 2, 1300083. [Google Scholar] [CrossRef] [PubMed]
 - Simmons, M.P.; Ochoterena, H. Gaps as characters in sequence-based phylogenetic analysis. Syst. Biol. 2000, 49, 369–381. [Google Scholar] [CrossRef] [PubMed]
 - Darriba, D.; Posada, D.; Kozlov, A.M.; Stamatakis, A.; Morel, B.; Flouri, T. ModelTest-NG: A new and scalable tool for the selection of DNA and protein evolutionary models. Mol. Biol. Evol. 2020, 37, 291–294. [Google Scholar] [CrossRef] [PubMed]
 - Schwarz, G. Estimating the dimension of a model. Ann. Stat. 1978, 6, 461–464. [Google Scholar] [CrossRef]
 - Kozlov, A.M.; Darriba, D.; Flouri, T.; Morel, B.; Stamatakis, A. RAxML-NG: A fast, scalable, and user-friendly tool for maximum likelihood phylogenetic inference. Bioinformatics 2019, 35, 4453–4455. [Google Scholar] [CrossRef] [PubMed]

| Species | Collection Number | Lab Code | Location of Isolation | GenBank Accession Number | |||
|---|---|---|---|---|---|---|---|
| tef1α | ITS | rpb2 | tub2 | ||||
| Ac. globosum * | CBS 332.67 T | Rhizosphere, Lucknow, India | KM655479 | ||||
| Ac. strumarium * | CBS 333.67 T | Soil, Lucknow, India | KC503252 | ||||
| Ch. afropilosum * | CBS 145.38 T | Unknown | KT214713 | ||||
| Ch. angustispirale * | CBS 137.58 T | Fraxinus sp., Tellerman forest, Baleshev region, Russia | KF001734 | ||||
| Ch. ascotrichoides * | CBS 113.83 | Gossypium humitectum, Argentina | KF001742 | ||||
| Ch. capillare * | CBS 128489 T | Animal hair, California, USA | KT214724 | NR_144860 | KT214686 | KT214760 | |
| Ch. cervicicola * | CBS 128492 T | Neck of Homo sapiens Texas, USA | KT214697 | ||||
| Ch. citrinum * | CBS 693.82 T | Rice field soil, Tochigi, Japan | KT214730 | NR_144863 | KT214691 | KT214764 | |
| Ch. coarctatum * | CBS 162.62 T | Seed of Cappanula medium, St. Petersburg, Russia, | KF001712 | ||||
| Ch. cochliodes | SZMC 22473 | T364 | Wall (swab), room, apartment Tatabánya, Hungary | MW556657 | |||
| Ch. cochliodes | SZMC 24764 | OT7 ** | Settled dust, office, Helsinki, Finland | MT498103 | |||
| Ch. cochliodes | SZMC 26528 | OT7b ** | Settled dust, office, Helsinki, Finland | MT498102 | |||
| Ch. cochliodes * | CBS 155.52 T | Animal dung, USA | KF001721 | NR_151835 | KF001811 | KC109772 | |
| Ch. contagiosum * | CBS 128494 T | Cornea of Homo sapiens, Northeast USA | KT214694 | NR_144846 | KT214659 | KT214732 | |
| Ch. cucumericola * | CBS 378.71 T | Izmir, Turkey | KT214718 | ||||
| Ch. elatum * | CBS 374.66 T | Decomposing leaf, Aptos, California, USA | KF001730 | ||||
| Ch. elatum * | CBS 142034 T | Cardboard, Denmark | KX976612 | KX976832 | KX976954 | ||
| Ch. fimeti * | CBS 139034 T | Soil, Germany | KT214698 | ||||
| Ch. globosporum * | CBS 108.83 T | Green leaf of Triticum aestivum, Germany | KF001735 | ||||
| Ch. globosum | SZMC 22474 | T365 | Air, hotel, Budapest, Hungary | MW556658 | |||
| Ch. globosum | SZMC 22478 | T369 | Air, shop, Szentendre, Hungary | MW556659 | MW541923 | ||
| Ch. globosum | SZMC 22481 | T372A | House dust, basement, flat, Budapest, Hungary | MW556660 | |||
| Ch. globosum | SZMC 22788 | T428B | Ceiling (swab), apartment, Budapest, Hungary | MW556661 | |||
| Ch. globosum | SZMC 23266 | T457D | Under ceramic tiles in a kitchen (swab), apartment, Csepel, Hungary | MW556662 | |||
| Ch. globosum | SZMC 23275 | T459A | Air, from gypsum board wall of a children’s room, house, Budapest, Hungary | MW556663 | |||
| Ch. globosum | SZMC 23688 | T499 | House dust (swab), living room, apartment, Budapest, Hungary | MW556664 | |||
| Ch. globosum | SZMC 24035 | T536A | Wall, kitchen, apartment, Budapest, Hungary | MW556665 | |||
| Ch. globosum | SZMC 24451 | C13/LM | Exhaust air filter, school, Vantaa, Finland | MW556666 | |||
| Ch. globosum | SZMC 24455 | C22/LM ** | Exhaust air filter, school, Vantaa, Finland | MT498109 | |||
| Ch. globosum | SZMC 24456 | MH5 ** | Settled dust, public building, Espoo, Finland | MT498108 | |||
| Ch. globosum | SZMC 24464 | MÖ9 ** | Settled dust, piggery, Orimattila, Finland | MT498106 | MW541924 | ||
| Ch. globosum | SZMC 24508 | T582D | Garage wall (swab), apartment, Budapest, Hungary | MW556667 | |||
| Ch. globosum | SZMC 24765 | 2c/26 | Settled dust, apartment, Vantaa, Finland | MW310244 | |||
| Ch. globosum | SZMC 24766 | 2b/26 ** | Settled dust, apartment, Vantaa, Finland | MT498110 | |||
| Ch. globosum | SZMC 24768 | C22 | Settled dust, apartment Vantaa, Finland | MW556668 | |||
| Ch. globosum | SZMC 24769 | MH52 ** | Settled dust, public building, Espoo, Finland | MT498107 | |||
| Ch. globosum | SZMC 24938 | 626C | Wall (swab), living room, house, Kazincbarcika, Hungary | MW556670 | |||
| Ch. globosum | SZMC 26530 | Ruk10 ** | Settled dust, apartment, Vantaa, Finland | MT498101 | MW541927 | ||
| Ch. globosum | SZMC 26534 | MTAV35 ** | Settled dust, University of Oulu, Finland | ||||
| Ch. globosum | SZMC 26539 | 3b/APP | Exhaust air filter, public building, Espoo, Finland | MW588207 | |||
| Ch. globosum | SZMC 26845 | T706 | Wall (swab), kitchen, apartment, Budapest, Hungary | MW556672 | |||
| Ch. globosum | SZMC 26857 | T711 | Wallpaper (swab), living room, apartment, Budapest, Hungary | MW556673 | |||
| Ch. globosum | SZMC 27052 | T730A | On paper packaging, imported from Sri Lanka, swab factory, Pécs, Hungary | MW556674 | |||
| Ch. globosum * | CBS 160.62 T | Compost, Germany | KT214704 | NR_144851 | KT214666 | KT214742 | |
| Ch. globosum * | MUCL 39526 T | Dead stem of Juncus sp., Hungary | KF001710 | ||||
| Ch. globosum * | CBS 666.82 | Unknown | KX976617 | KX976833 | KX976959 | ||
| Ch. graminiforme * | CBS 506.84 T | Acer sp., Muskoka District, Ontario, Canada | KT214725 | ||||
| Ch. grande * | CBS 126780 T | Leaf of Triticum aestivum, Naghadeh, Iran | KT214692 | ||||
| Ch. interruptum | SZMC 23937 | T531B | Under wallpaper (swab), office, Budapest, Hungary | MW588206 | MW301425 | ||
| Ch. interruptum * | CBS 126660 T | Seed of Triticum aestivum, Hadishahr East Azerbaijan Province, Iran | KT214703 | KT214564 | KT214665 | ||
| Ch. madrasense * | CBS 315.74 T | Rhizosphere of Pennisetum typhoides, Chennai, Tamil Nadu, India | KF001741 | ||||
| Ch. novozelandicum * | CBS 124555 T | Dead decaying twig, Otaki, New Zealand | KT214715 | ||||
| Ch. pilosum * | CBS 335.67 T | Grain of Triticum aestivum, Perth, Western Australia | KT214729 | NR_144862 | FJ666387 | KT214763 | |
| Ch. pseudocochliodes * | CGMCC 3.9441 T | Roots of Panax notoginseng, Wenshan, Yunnan Province, China | KF001726 | ||||
| Ch. pseudoglobosum * | CBS 574.71 T | Unknown | KT214712 | ||||
| Ch. rectangulare | SZMC 26531 | MO13 ** | Settled dust, piggery, Orimattila, Finland | MT498104 | MW541928 | ||
| Ch. rectangulare | SZMC 26535 | MO15 ** | Settled dust, piggery, Orimattila, Finland | MT498105 | MW541929 | ||
| Ch. rectangulare * | CBS 126778 T | Leaf of Hordeum vulgare, Salmas, West Azerbaijan province, Iran | KT214726 | NR_144817 | HM365285 | KT214688 | |
| Ch. spiculipilium * | CBS 373.66 T | Decaying vegetable debris, California, USA | KF001719 | ||||
| Ch. spirochaete * | CBS 730.84 T | Animal dung, Great Smokey Mountains, Tennessee, USA | KF001729 | NR_144823 | KF001819 | JN256191 | |
| Ch. subaffine * | CBS 637.91 T | Cereal, USSR | KF001727 | ||||
| Ch. subfimeti * | CBS 370.66 T | Paper and vegetable material, Cardiff, Wales | KT214701 | NR_144850 | FJ666385 | KT214739 | |
| Ch. subglobosum * | CBS 149.60 T | Dead herbaceous stem, St. Petersburg, Russia | KF001718 | ||||
| Ch. telluricola * | CBS 151.59 T | Soil, Suffolk, Lakenheath Warren, United Kingdom | KT214723 | ||||
| Ch. tenue * | CBS 139.38 T | Unknown | KT214707 | ||||
| Ch. umbonatum * | CBS 293.83 T | Soil, Nova Scotia, Canada | KT214714 | ||||
| Ch. undulatulum * | CBS 126775 T | Leaf of Hordeum vulgare, Bonab, East Azerbaijan province, Iran | KT214720 | ||||
| Ch. unguicola * | CBS 128446 T | Nail of Homo sapiens, Los Angeles, USA | KT214706 | ||||
| Ch. megalocarpum * | CBS 149.59 T | Leaf of Ficus carica, Greece | KF001738 | ||||
| D. dolichotrichus * | CBS 162.48 T | USA | KC485023 | HM449049 | KX976852 | JF772462 | |
| D. erectus * | CBS 140.56 T | Petroselinum sativum, USA | KC485018 | HM449044 | KX976854 | JF772458 | |
| D. funicola * | CBS 159.52 T | Germany | KC485013 | GU563369 | KX976856 | JF772461 | |
| D. funicola * | CBS 136.38 | Unknown | KX976857 | ||||
| D. funicola * | DTO 333-F1 | Dust, outdoors, Denmark | KX976658 | KX976858 | KX977000 | ||
| D. fusus * | CBS 372.66 T | Unknown | KM655463 | KM655333 | KX976859 | KX977002 | |
| D. indicus * | CGMCC 3.14184 T | Rhizosphere of Panax Notoginseng, Wenshan county, Yunnan Province | KC485005 | GU563367 | KX976861 | JF772453 | |
| D. pratensis * | CGMCC 3.14181 T | Soil, Huangnan, Qinghai Province, China | KC485017 | GU563372 | KX976866 | JF772450 | |
| D. pseudoerectus * | CBS 252.75 T | Air, Uttar Pradesh, India | NR_147674 | KX976869 | KX977009 | ||
| D. pseudofunicola * | CBS 142033 T | Dust, USA | KX976668 | KX976870 | KX977010 | ||
| D. ramosissimus * | CGMCC 3.14183 T | Rhizosphere of Panax notoginseng, Wenshan county, Yunnan Province, China | KC485021 | GU563371 | KX976871 | JF772452 | |
| D. reflexus * | CBS 157.49 T | Germinating seed, USA | KC485027 | HM449051 | KX976873 | JF772460 | |
| D. subfunicola * | CGMCC 3.12892 T | Soil, Shihezi, Xinjiang Autonomous Region, China | KC485014 | JX867125 | KX976875 | JX867122 | |
| D. subfunicola * | CGMCC 3.9466 | Rhizosphere of Panax notoginseng, Yunnan, China | KC485016 | GU563368 | KX976876 | JF772446 | |
| D. subfunicola * | CBS 794.83 | Paper, Switzerland | GU563368 | KX976876 | KX977013 | ||
| D. subfunicola * | CBS 812.73 | Pistol belt, New Guinea | KX976670 | KX976877 | KX977012 | ||
| D. variostiolatus * | CBS 179.84 | Tarpaulin, New Guinea | NR_147676 | KX976879 | KX977014 | ||
| D. variostiolatus * | DTO 319-B9 | Dust, Thailand | KX976674 | KX976881 | KX977016 | ||
| D. variostiolatus * | DTO 319-A2 | Dust, USA | KX976673 | KX976880 | KX977015 | ||
| Dichotomopilus sp. | SZMC 26527 | C5/LM | Exhaust air filter, school, Vantaa, Finland | MW556671 | MW541925 | MZ665530 | MZ665528 | 
| Dichotomopilus sp. | SZMC 26529 | Ch1/tu ** | Inlet air filter, public building, Espoo, Finland | MT644127 | MW541926 | MZ665531 | MZ665529 | 
| Gene | Primer | PCR Condition | |
|---|---|---|---|
| tef1α | 
                EF1-728F: CATCGAGAAGTTCGAGAAGG TEF1-LLErev: AACTTGCAGGCAATGTGG  | 94 °C 5 min![]() 72 °C 7 min  | 40 cycles | 
| ITS | ITS1: TCCGTAGGTGAACCTGCGG ITS4: TCCTCCGCTTATTGATATGC  | 94 °C 2 min![]() 72 °C 2 min  | 35 cycles | 
| tub2 | BT2a: GGTAACCAAATCGGTGCTGCTTTC BT2b: ACCCTCAGTGTAGTGACCCTTGGC  | 94 °C 2 min![]() 72 °C 7 min  | 35 cycles | 
| rpb2 | RPB2 5F_Eur: GAYGAYCGKGAYCAYTTCGG RPB2 7CR_Eur: CCCATRGCYTGYTTRCCCAT  | 94 °C 5 min | |
![]()  | 5 cycles | ||
![]()  | 5 cycles | ||
![]()  | 30 cycles | ||
| 72 °C 7 min | 
| Partition | Best-Fit Model | 
|---|---|
| rpb2 | TrN + G4 | 
| tef1α | TIM2 + G4 | 
| tub2 intron | HKY + G4 | 
| tub2 exon | TrN + G4 | 
| rDNA | F81 + G4 | 
| ITS | TIM2 + G4 | 
| Indel | BIN + ASC_LEWIS | 
Publisher’s Note: MDPI stays neutral with regard to jurisdictional claims in published maps and institutional affiliations.  | 
© 2021 by the authors. Licensee MDPI, Basel, Switzerland. This article is an open access article distributed under the terms and conditions of the Creative Commons Attribution (CC BY) license (https://creativecommons.org/licenses/by/4.0/).
Share and Cite
Kedves, O.; Kocsubé, S.; Bata, T.; Andersson, M.A.; Salo, J.M.; Mikkola, R.; Salonen, H.; Szűcs, A.; Kedves, A.; Kónya, Z.; et al. Chaetomium and Chaetomium-like Species from European Indoor Environments Include Dichotomopilus finlandicus sp. nov. Pathogens 2021, 10, 1133. https://doi.org/10.3390/pathogens10091133
Kedves O, Kocsubé S, Bata T, Andersson MA, Salo JM, Mikkola R, Salonen H, Szűcs A, Kedves A, Kónya Z, et al. Chaetomium and Chaetomium-like Species from European Indoor Environments Include Dichotomopilus finlandicus sp. nov. Pathogens. 2021; 10(9):1133. https://doi.org/10.3390/pathogens10091133
Chicago/Turabian StyleKedves, Orsolya, Sándor Kocsubé, Teodóra Bata, Maria A. Andersson, Johanna M. Salo, Raimo Mikkola, Heidi Salonen, Attila Szűcs, Alfonz Kedves, Zoltán Kónya, and et al. 2021. "Chaetomium and Chaetomium-like Species from European Indoor Environments Include Dichotomopilus finlandicus sp. nov." Pathogens 10, no. 9: 1133. https://doi.org/10.3390/pathogens10091133
APA StyleKedves, O., Kocsubé, S., Bata, T., Andersson, M. A., Salo, J. M., Mikkola, R., Salonen, H., Szűcs, A., Kedves, A., Kónya, Z., Vágvölgyi, C., Magyar, D., & Kredics, L. (2021). Chaetomium and Chaetomium-like Species from European Indoor Environments Include Dichotomopilus finlandicus sp. nov. Pathogens, 10(9), 1133. https://doi.org/10.3390/pathogens10091133
        
                                                

       




